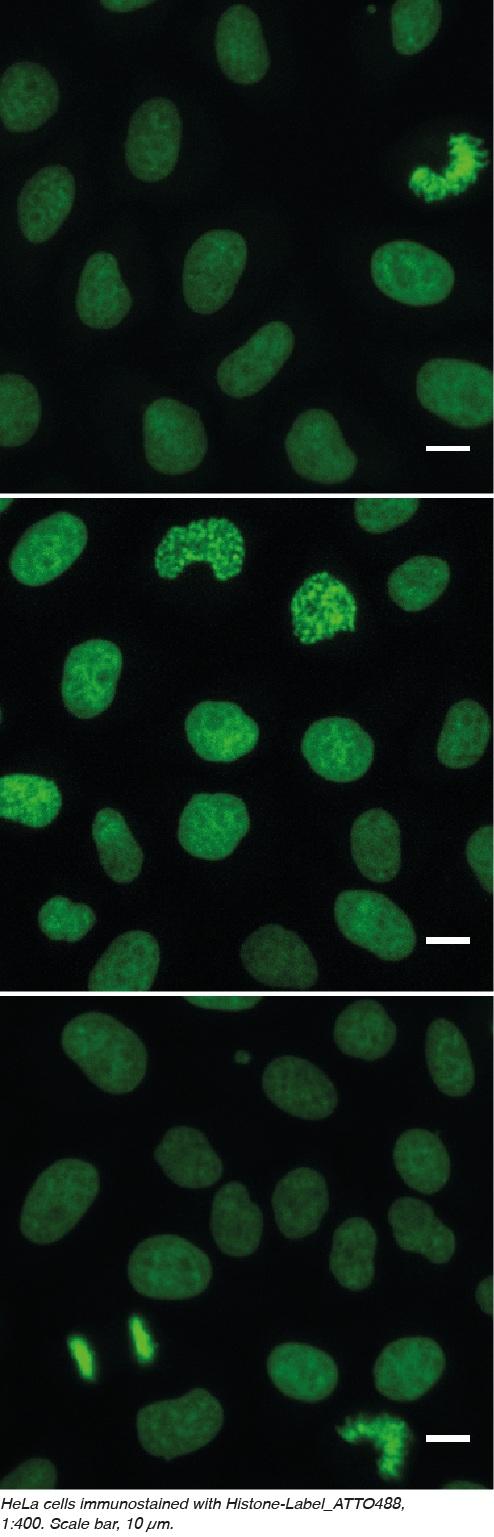

Histone-Label®(Histoneラベル®)は、Histoneタンパク質の免疫蛍光染色(IF:Immunofluorescence)実験に最適な蛍光色素標識済みのアルパカ由来Histone抗体です。
蛍光色素には、アルパカ(Alpaca)を宿主動物(免疫動物)として作製された「抗Histone組換えモノクローナルVHH抗体」が結合しています。VHH抗体は、NANOBODY® としても知られるラクダ科動物の「重鎖抗体(Heavy chain-only antibody)」由来の抗原結合ドメインであり、高い特異性と親和性を示します。VHH抗体は、一般的の抗体よりもサイズが小さく浸透性が高いため、細胞染色に最適です。






















このページを印刷する